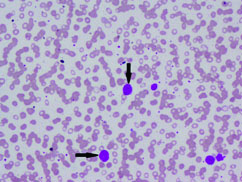

Blastoid Variant of Mantle Cell Lymphoma with Leukemic Presentation - A Rare Case Report
Ruchee Khanna1, Sushma Belurkar2, P. Lavanya3, Chethan Manohar4, Manna Valiathan5
1 Associate Professor, Department of Pathology, Kasturba Medical College, Manipal, Karnataka, India.
2 Associate Professor, Department of Pathology, Kasturba Medical College, Manipal, Karnataka, India.
3 Tutor, Department of Pathology, Kasturba Medical College, Manipal, Karnataka, India.
4 Professor, Department of Pathology, Kasturba Medical College, Manipal, Karnataka, India.
5 Professor, Department of Pathology, Kasturba Medical College, Manipal, Karnataka, India.
NAME, ADDRESS, E-MAIL ID OF THE CORRESPONDING AUTHOR: Dr. Sushma Belurkar, Department of Pathology, Kasturba Medical College, Manipal-576104, Karnataka, India.
E-mail: sushbelur@gmail.com
Mantle Cell Lymphoma (MCL) is a type of Non-Hodgkin’s lymphoma and has a wide spectrum of histopathological subtypes of which the blastoid or the blastic variant constitutes 10-15% of all cases. It is difficult to diagnose blastoid variant of MCL on the basis of morphology alone as it mimics lymphoblastic lymphoma and centroblastic large cell lymphoma, hence additional analysis like immunophenotyping and molecular studies aid in its diagnosis.
We present a case of 45-year-old male who presented to medicine OPD with chief complaints of fever, fatigability and inguinal swelling. Complete blood count, peripheral smear and bone marrow examination was performed. Peripheral smear showed thrombocytopenia along with 53% abnormal cells. On bone marrow examination 43% abnormal lymphoid cells were seen. This case was diagnosed as blastoid variant of MCL on the basis of routine morphology and immunohistochemistry on bone marrow biopsy and flow cytometric immunophenotyping on peripheral blood.
Flow cytometry, Hepatomegaly, Non-Hodgkin’s lymphoma
Case Report
A 45-year-old male patient presented to medicine OPD with chief complaints of fever, easy fatigability and right sided inguinal swelling. On physical examination, there was enlarged right sided inguinal lymph node, along with massive splenomegaly (16-18 cm below the left costal margin) and hepatomegaly (5-6 cm below the right costal margin).
Complete blood count and peripheral smear showed thrombocytopenia and 53% abnormal cells which resembled lymphoblast [Table/Fig-1,2]. Bone marrow aspirate smears were dilute and showed 43% abnormal lymphoid cells which were medium to large sized with high N:C ratio dense nuclear chromatin, scant cytoplasm and few showing irregular nuclear margins and inconspicuous nucleoli [Table/Fig-3,4]. Trephine biopsy showed interstitial and paratrabecular infiltration by abnormal lymphoid cells which were medium sized with dispersed nuclear chromatin and irregular nuclear margins along with few interspersed large cells with convoluted nucleus showing 1-2 prominent nucleoli [Table/Fig-5].
Abnormal cells in peripheral smear (arrow) (Leishman stain; 10X).
Abnormal cells in peripheral smear (arrow) (Leishman stain; 40X).

Abnormal cells in bone marrow (arrow) (Leishman stain; 20X).

Abnormal cells in bone marrow (arrow) (H&E; 10X).

Interstitial abnormal lymphoid infiltrate in bone marrow biopsy (40X Hematoxylin and Eosin stain).

Immunohistochemistry was done on bone marrow biopsy with the following IHC markers: Cyclin D1 was positive in >10% abnormal cells. BCL2 was positive in the abnormal cells but BCL6 was negative [Table/Fig-6,7].
Cyclin D1 positive in the abnormal cells (40X).

BCL2 positive in the abnormal cells (20X).

Flow cytometric analysis was performed on peripheral blood and the cells were bright CD45 positive which confirmed that the abnormal cells were mature lymphoid cells and not blasts. The immune phenotyping revealed positive B cell markers CD20, CD19, CD79a (Dim), CD23 (Heterogeneous) with surface kappa restriction, and positive CD5. The cells were negative for other T cell markers, myeloid markers, monocytic markers, CD10, sCD34 and CD15 [Table/Fig-8,9,10 and 11].
Flowcytometry image : Bright CD45 cells with higher side scatter than the normal lymphocytes were gated as abnormal cells.

Abnormal cells positive for CD19 and CD20 with kappa restriction and negative for CD10 and CD34.

Abnormal cells positive for CD5 but negative for other T cell markers CD3, CD4 and CD8.

Abnormal cells negative for CD36,CD14,CD13 and CD 33 and variably positive for CD23.

Inguinal lymph node biopsy was done. Grossly four lymph nodes were identified which on microscopy showed diffuse effacement of nodal architecture with sheets of medium sized lymphoid cells with scant cytoplasm, pleomorphic round to oval nuclei, irregular nuclear contours, condensed nuclear chromatin, inconspicuous nucleoli and mitosis (<10/10HPF) along with interspersed high endothelial venules and congested thick walled blood vessels.
So, it was diagnosed as MCL then chemotherapeutic regimen was given to the patient. He completed four cycles of therapy after which the patient was lost for follow up.
Discussion
MCL constitutes 3-10% of Non-Hodgkins Lymphomas. It usually occurs in middle aged to older adults with a median age of 60 years and has a male predominance. MCL is a subtype of B-cell Non- Hodgkins lymphoma arising from naive pre germinal center B cell within the mantle zone that surrounds normal germinal center. These cells show over expression of cyclin D1 due to the chromosomal translocation t (11;14)(q13;q32) [1].
The presentation is usually at an advanced stage III or IV with lymphadenopathy, hepatosplenomegaly and bone marrow involvement. A 30-50% of cases present with systemic symptoms like weight loss, fever and night sweat [2]. The primary site of involvement is lymph node which is often generalized. The other common sites involved are spleen and bone marrow with or without peripheral blood involvement. The frequently involved extra nodal site is gastrointestinal tract and Waldeyer ring [3].
The morphology of classical MCL is monomorphic proliferation of lymphoid cells with diffuse, vaguely nodular, mantle zone or in rare instances follicular growth pattern. The lymphoid cells are small to medium sized with mild to marked irregular nuclear contours usually resembling centrocytes. The nuclei has somewhat dispersed chromatin with inconspicuous nucleoli. Although, histological transformation to large cell lymphoma doesn’t occur, relapse is associated with the absence of mantle zone growth pattern, increased nuclear size, pleomorphism, dispersed chromatin, and high mitotic activity [3].
MCL has a broad spectrum of several histopathological variants of which blastoid variant constitutes 10-15% of all cases [4]. Other variants of MCL include the pleomorphic type, small cell type and the marginal zone like [1]. There is no much difference in the clinico biological presentation between the blastoid variant and the classical forms of MCL [2].
The blastoid variant differs from the classical MCL as the cells resemble lymphoblast with more dispersed chromatin and has a very high mitotic activity (at least 20-30/10HPF). The pleomorphic variant is characterized by the presence of pleomorphic cells of which many are large cells with oval to irregular nuclear contours, pale cytoplasm, prominent nucleoli and increased mitotic figures resembling large cell lymphoma [5].
The cells express surface IgM/IgD and are usually lambda restricted. The cells are positive for CD5, FMC7 and CD43 and negative for CD10, BCL6 and CD23. Aberrant phenotype can be seen in the form of absence of CD5, expression of BCL6 and CD10. BCL2 is positive in all cases and cyclin D1 is frequently expressed in almost all cases even in minority of cases showing absence of CD5 [6].
Our case though morphologically was blastoid variant, showed positivity for CD5 and was CD10 negative. Another unique feature was kappa restriction. But Cyclin D1 and BCL2 positivity confirmed the diagnosis.
The differential diagnosis of blastoid variant includes centroblastic large cell lymphoma and lymphoblastic lymphoma. But the characteristic immunophenotype in the blastoid variant reveals a mantle cell pattern [5].
The adverse prognostic factors include very high leukocyte count, high mitotic activity, increased ki 67 index, pleomorphic or blastoid morphology and overt peripheral blood involvement [3].
MCL has a poor prognosis with a median overall survival of 3 to 5 years with the administration of standard therapy. The blastoid variant is more aggressive and is refractory to chemotherapy. It has a very poor prognosis and poorer overall survival indicating that it is one of the worst forms of Non-Hodgkin’s lymphoma [2]. In our case as the patient was lost for follow up the overall survival and prognosis could not be assessed.
Conclusion
The blastoid variant of MCL is a rare type of Non-Hodgkin lymphoma which carries an overall poor prognosis. Immuophenotyping and flow cytometry is a must for correct diagnosis because recognizing blastoid variant carries prognostic significance.
[1]. Mckay P, Leach M, Jackson R, Cook G, Rule S, Guidelines for the investigations and management of mantle cell lymphomaBritish Journal of Haematology 2012 (10):405-26. [Google Scholar]
[2]. Sen R, Gupta S, Gill M, Kohli R, Gupta V, Verma R, Blastoid variant of mantle cell lymphoma: A rare case reportAmerican Journal of Medical Case Reports 2014 2(8):161-63. [Google Scholar]
[3]. Swerdlow SH, Campo E, Harris NL, WHO Classification of Tumours of Haematopoietic and Lymphoid TissuesInternational Agency for Research on Cancer, Lyon 2008 4th edition [Google Scholar]
[4]. Bernard M, Gressin R, Lefrere F, Drenou B, Branger B, Caulet-Maugendre S, Blastic variant of mantle cell lymphoma: A rare but highly aggressive subtypeLeukemia 2001 15(11):1785-91. [Google Scholar]
[5]. Ott G, Kalla J, Ott MM, Schryen B, Katzenberger T, Müller JG, Blastoid variants of mantle cell lymphoma: Frequent bcl-1 rearrangements at the major translocation cluster region and tetraploid chromosome clonesBlood 1997 89:1421-29. [Google Scholar]
[6]. Morice WG, Hodnefield JM, Kurtin PJ, Hanson CA, An unusual case of leukemic mantle cell lymphoma with a blastoid component showing loss of CD5 and aberrant expression of CD10Am J Clin Pathol 2004 (10):122-27. [Google Scholar]